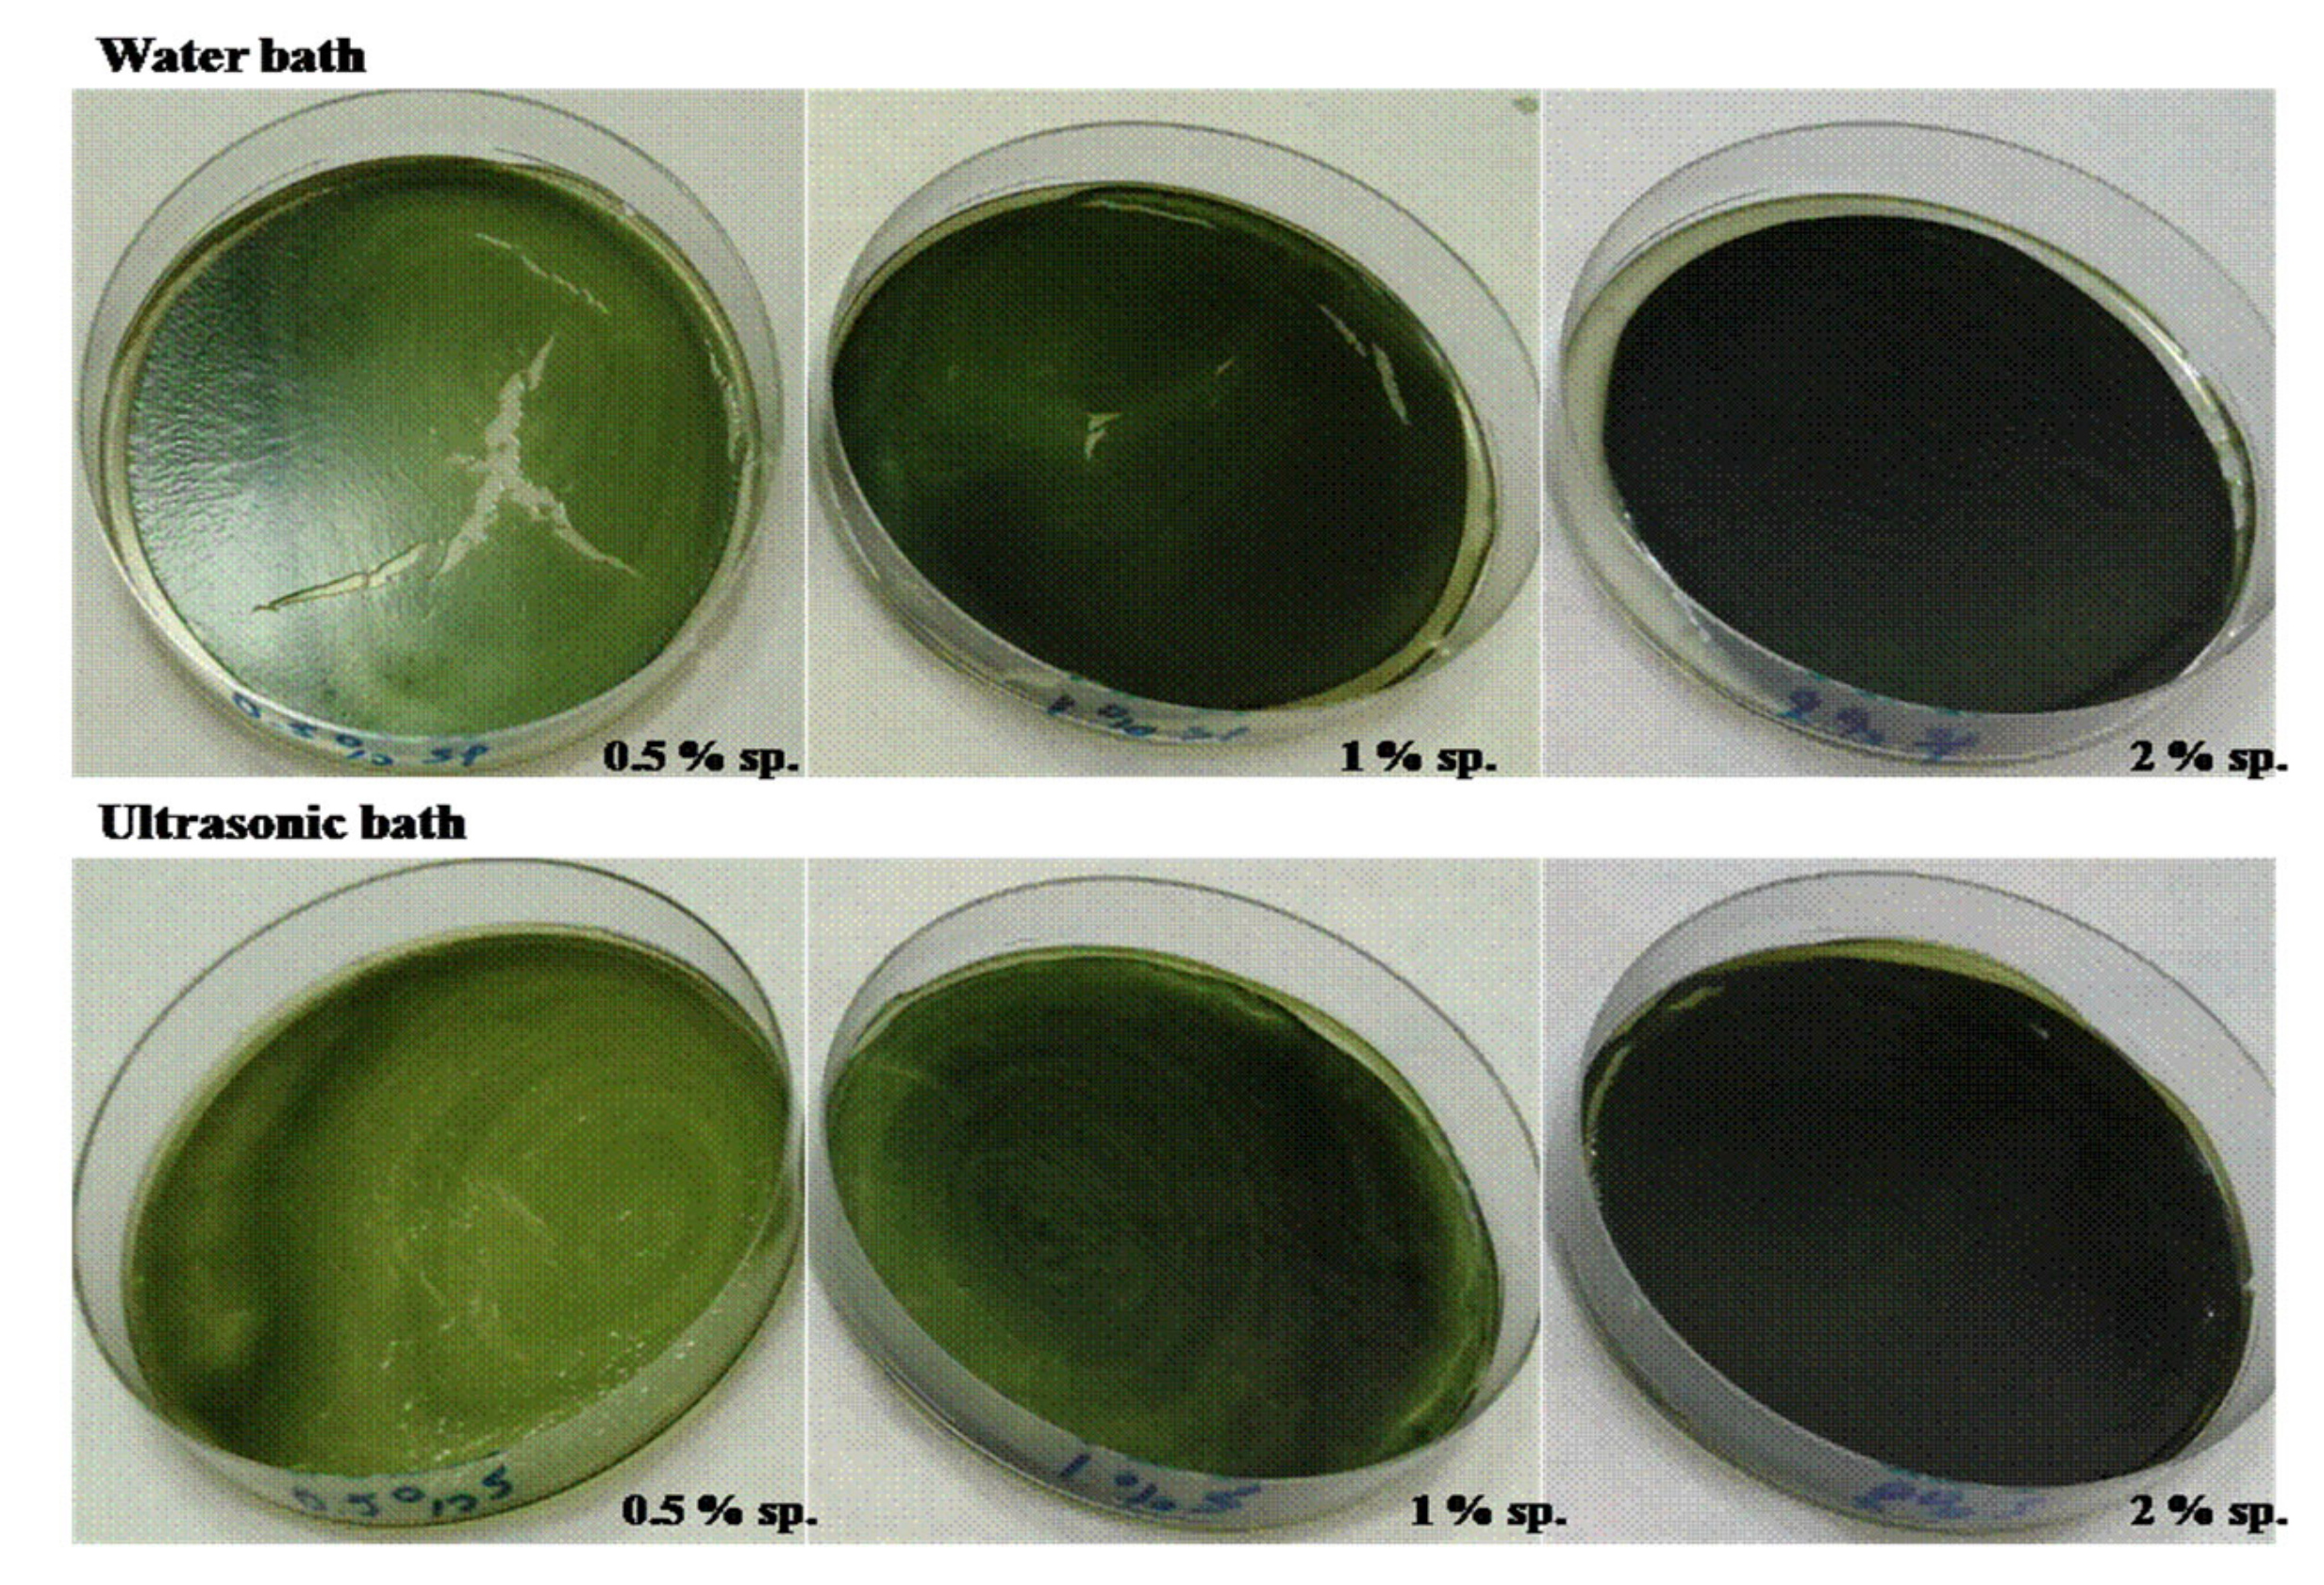

Evaluation of the Antioxidant and Physicochemical Properties of Microalgae/Whey Protein-Based Edible Films †
Abstract
:1. Introduction
2. Materials and Methods
2.1. Chemicals, and Standards
2.2. Film Preparation
2.3. Thickness
2.4. Water Behavior
2.5. Determination of Mechanical Properties
2.6. Antioxidant Properties
2.7. Attenuated Total Reflection Fourier-Transform Infrared Spectroscopy (ATR-IR) Analysis
3. Results and Discussion
3.1. Whey Protein Active Packaging Incorporated with Microalgae
3.2. Moisture Content, Solubility in Water, Swelling Index and Film Thickness
3.3. Mechanical Properties of the Edible Films
3.4. Antioxidant Properties
3.5. Attenuated Total Reflection Fourier-Transform Infrared Spectroscopy (ATR-IR) Analysis
4. Conclusions
Author Contributions
Funding
Institutional Review Board Statement
Informed Consent Statement
Data Availability Statement
Conflicts of Interest
References
- Daniloski, D.; Trajkovska Petkoska, A.; Lee, N.A.; El-Din Bekhit, A.; Carne, A.; Vaskoska, R.; Vasiljevic, T. Active edible packaging based on milk proteins: A route to carry and deliver nutraceuticals. Trends Food Sci. Technol. 2021, 111, 688–705. [Google Scholar] [CrossRef]
- Behestipour, H.; Mortazavian, A.M.; Mohammadi, R.; Sohrabvandi, S.; Khosravi-Darani, K. Supplementation of Spirulina platensis and Chlorella vulgaris Algae into Probiotic Fermented Milks. Compr. Rev. Food Sci. Food Saf. 2013, 12, 144–154. [Google Scholar] [CrossRef]
- García, A.; Pérez, L.M.; Piccirilli, G.N.; Verdini, R.A. Evaluation of antioxidant, antibacterial and physicochemical properties of whey protein-based edible films incorporated with different soy sauces. LWT 2020, 117, 108587. [Google Scholar] [CrossRef]
- Jamroz, E.; Kulawik, P.; Krzyściak, P.; Talaga-Ćwiertnia, K.; Juszczak, L. Intelligent and active furcellaran-gelatin films containing green or pu-erh tea extracts: Characterization, antioxidant and antimicrobial potential. Int. J. Biol. Macromol. 2019, 122, 745–757. [Google Scholar] [CrossRef] [PubMed]
- Pluta-Kubica, A.; Jamróz, E.; Kawecka, A.; Juszczak, L.; Krzyściak, P. Active edible furcellaran/whey protein films with yerba mate and white tea extracts: Preparation, characterization and its application to fresh soft rennet-curd cheese. Int. J. Biol. Macromol. 2020, 155, 1307–1316. [Google Scholar] [CrossRef] [PubMed]
- Barkallah, M.; Dammak, M.; Louati, I.; Hentati, F.; Hadrich, B.; Mechichi, T.; Ayadi, M.A.; Fendri, I.; Attia, H.; Abdelkafi, S. Effect of Spirulina platensis fortification on physicochemical, textural, antioxidant and sensory properties of yogurt during fermentation and storage. LWT 2017, 84, 323–330. [Google Scholar] [CrossRef]
- Ramos, Ó.L.; Reinas, I.; Silva, S.I.; Fernandes, J.C.; Cerqueira, M.A.; Pereira, R.N.; Vicente, A.A.; Poças, M.F.; Pintado, M.E.; Malcata, F.X. Effect of whey protein purity and glycerol content upon physical properties of edible films manufactured therefrom. Food Hydrocoll. 2013, 30, 110–122. [Google Scholar] [CrossRef] [Green Version]
- Jiang, L.; Jia, F.; Han, Y.; Meng, X.; Xiao, Y.; Bai, S. Development and characterization of zein edible films incorporated with catechin/β-cyclodextrin inclusion complex nanoparticles. Carbohydr. Polym. 2021, 261, 117877. [Google Scholar] [CrossRef] [PubMed]
- Jiang, L.; Liu, F.; Wang, F.; Zhang, H.; Kang, M. Development and characterization of zein-based active packaging films containing catechin loadedβ-cyclodextrin metal-organic frameworks. Food Packag. Shelf Life 2022, 31, 100810. [Google Scholar] [CrossRef]

| Film | Thickness (mm) | MC (%) | S (%) | SW (%) | TS (MPa) | YM (MPa) | E (%) |
|---|---|---|---|---|---|---|---|
| Control | 0.188 ± 0.038 | 26.48 ±1.71 | 18.82 ± 0.33 | 8.78 ± 0.90 | 0.69 ± 0.07 | 10.16 ± 1.79 | 51.09 ± 5.69 |
| 0.5% sp. | 0.181 ± 0.015 | 27.71 ± 0.47 | 18.91 ± 0.17 | 8.48 ± 1.02 | 0.89 ± 0.04 | 11.9 ± 1.73 | 22.76 ± 2.78 |
| 1% sp. | 0.207 ± 0.044 | 22.74 ± 1.40 | 20.68 ± 1.48 | 10.90 ± 0.92 | 1.35 ± 0.09 | 19.00 ± 1.75 | 17.88 ± 0.91 |
| 2% sp. | 0.193 ± 0.005 | 21.88 ± 0.46 | 21.06 ± 0.47 | 14.60 ± 1.04 | 2.55 ± 0.36 | 23.15 ± 2.82 | 12.10 ± 1.40 |
| 4% sp. | 0.250 ± 0.018 | 15.70 ± 0.39 | 21.60 ± 0.08 | 18.75 ± 1.45 | 1.43 ± 0.27 | 28.31 ± 0.35 | 9.44 ± 1.38 |
Publisher’s Note: MDPI stays neutral with regard to jurisdictional claims in published maps and institutional affiliations. |
© 2021 by the authors. Licensee MDPI, Basel, Switzerland. This article is an open access article distributed under the terms and conditions of the Creative Commons Attribution (CC BY) license (https://creativecommons.org/licenses/by/4.0/).
Share and Cite
Kontogianni, V.G.; Chatzikonstantinou, A.V.; Mataragas, M.; Kondyli, E.; Stamatis, H.; Bosnea, L. Evaluation of the Antioxidant and Physicochemical Properties of Microalgae/Whey Protein-Based Edible Films. Biol. Life Sci. Forum 2021, 6, 97. https://doi.org/10.3390/Foods2021-10926
Kontogianni VG, Chatzikonstantinou AV, Mataragas M, Kondyli E, Stamatis H, Bosnea L. Evaluation of the Antioxidant and Physicochemical Properties of Microalgae/Whey Protein-Based Edible Films. Biology and Life Sciences Forum. 2021; 6(1):97. https://doi.org/10.3390/Foods2021-10926
Chicago/Turabian StyleKontogianni, Vasiliki G., Alexandra V. Chatzikonstantinou, Marios Mataragas, Efthymia Kondyli, Haralambos Stamatis, and Loulouda Bosnea. 2021. "Evaluation of the Antioxidant and Physicochemical Properties of Microalgae/Whey Protein-Based Edible Films" Biology and Life Sciences Forum 6, no. 1: 97. https://doi.org/10.3390/Foods2021-10926
APA StyleKontogianni, V. G., Chatzikonstantinou, A. V., Mataragas, M., Kondyli, E., Stamatis, H., & Bosnea, L. (2021). Evaluation of the Antioxidant and Physicochemical Properties of Microalgae/Whey Protein-Based Edible Films. Biology and Life Sciences Forum, 6(1), 97. https://doi.org/10.3390/Foods2021-10926

